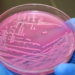
E.coli

In 2021, Ted Williams III won a grant from the Illinois Arts Council to commemorate the 400-year anniversary of African Americans. “1619: The Journey of a People” is a new production that premiered at Kennedy-King College in Chicago this summer. Told through the multi-disciplinary tool of musical theater, it strives to convey a sizable piece of this history while taking an unflinching look at America’s current conditions. Although the anniversary of the first enslaved to arrive in the US has been commemorated in multiple ways, Mr. Williams felt particularly called to use theater. This medium has long been an unparalleled tool for transmitting the stories of history.
Since the Illinois Arts Council funded the world premiere in August of 2019, the production has been performed throughout Chicago and at various locations including the City of Clarksville, Tennessee, Elmhurst College, Wheaton College, the House of Hope, and Hampton University in Hampton, Virginia. It has been featured in various media outlets and was recently nominated for the 2020 August Wilson Award for the Best Writing of a Musical by the Black Theater Alliance Awards.

Williams told the Chicago Leader that “the process of creating a theatrical production was daunting, even though this was my second major musical effort. I wanted to tell the stories in a way that infused contemporary issues from the onset. Often when people think about a historic project, they assume a clear chronological approach that respects tradition and the limits of time and space. This was the very opposite of what I hoped to accomplish.”
The show immediately opens with “The Journey,” a hip-hop and African musical fusion that purposely uses dance to tie centuries of people together through the power of rhythm. It then moves into a look at the Trans-Atlantic Slave Trade through a piece called Captured. Audiences would expect to then be carried directly through the next two hundred and fifty years of American slavery. Williams told the Leader that “as a writer and artist, predictability is a cardinal sin. Therefore, the piece jumps immediately into a contemporary space where a modern character conveys a comedic connection to this difficult story.”
From this point, there are various modern personalities that pop in and out of the story. Each one brings their own unique perspective and artistic form of expression. Interspersed through their pieces is historic information about the Antebellum South, Reconstruction, the Great Migration, Jim Crow, the Civil Rights movement, the Black Lives Matter movement, and the host of legendary historic figures who’ve pushed the needle towards justice in this nation.

It was important to Williams that the show moved out of the traditional slavery story quickly to face the extensive fight for justice and equality. As a result, he tackled important questions about what it means to be an American historically and controversial current issues like the NFL protests and police brutality. Comedy, music, and storytelling are the balm that makes these difficult discussions more palatable. While he attempted to treat issues with respect, he also felt called to find points of humor and celebration designed to allow audiences an opportunity to exhale. Musically, Ted wanted a reflection of multiple eras and the emotional conflict that accompany them. Therefore, the selections include blues, jazz, hip-hop, funk, traditional djembe drum pieces, and a Negro spiritual.
“I Thought We Were Free” is a 7-minute musical journey through the Reconstruction era. Part comedy, tragedy, and defiant social commentary, it is the most historically instructive piece in the production. Booker T and WEB is a hip-hop debate between two starkly different ideologies for social progress, while Something for the Pain is a jazzy exploration of the impact of collective trauma on interpersonal relationships. The piece that is most personal to Williams is a spoken word piece he performed entitled After the Dream. “Living in the Trump era has been the source of anxiety for many people of color. Erroneously, I assumed that this nation had moved past much of its historic xenophobic rhetoric and actions. However, the rise in these kinds of expressions in the current culture has left art as one of the only safe forms of political expression. Thus, After the Dream is an artistic statement that boldly ties the spirit of Dr. King to the unapologetic battles waged by today’s racial equality movements.”

Another personal piece is a funk/rock/hip hop song entitled “I’m Not Black.” With this piece, Williams told the Leader that he wanted to challenge conventional nomenclature surrounding racial identity.
He says: “While blackness has been embraced heavily as a countercultural point of pride, I am not satisfied with the label. It is not only limiting but carries with it a certain set of pejoratives that subtly reinforce societal inequities. Purposely controversial and defiant, “I’m Not Black” has thus far been the song that has generated the most audience discussion. Our finale piece, Chains are Gone, is a triumphant musical theater celebration of the 400-year journey. It reminds us that on the other side of trial lies greatness. As a conflicted person of color, who has seen the blatant hypocrisy of our nation yet takes great pride in American citizenship, I wanted to end this work on a positive note. Music has always given hope even through perilous times. Chains are Gone is a declaration that our best days are still in front of us.”
As a person of faith, Mr. Williams is committed to the concepts of atonement and remembrance. The ancient Jewish community was told to constantly remember its collective heritage. In the Torah, this concept appears over 130 times. They established elaborate festivals, holidays, and memorials to commemorate their passage out of slavery and shared trials. The stories of 400 years in Egyptian bondage and 40 years of wandering in the desert were diligently passed to each generation. Following the Holocaust, modern Jews adopted the phrase “Zachor” as a rallying cry. It is a term that means to never forget the past as its imprint on our lives serves as a guide to the future.
Williams clarifies the meaning behind 1619 suggesting that “Many Americans want to forget this nation’s past, assuming that discussions about the impact of slavery only serve to fuel further division. Recalling our journey in this nation is hardly an effort to divide or perpetuate victimhood. Rather, it is an admonition to America-a reminder of its promise to all people. It helps us to understand the source of our present conditions and to have the capacity to address them honestly and holistically. This is hard work. It requires empathy, humility, patience, and courage. I hope 1619: The Journey of a People can be a part of a much-needed national reckoning.”
“1619: The Journey of a People” will be showing at the Vittum Theater located at 1012 N. Noble St. on June 17 at 7:30 p.m., June 18 at 1 p.m. and 6 p.m., and June 19 at 4 p.m. You can learn more at www.1619musical.com.
Written by DiMarkco Chandler
Source:
Interview: Ted Williams III
1619: The Journey of a People
Guardian Liberty Voice: 1619: The Journey of a People – Review
Images Courtesy of Ted Williams III